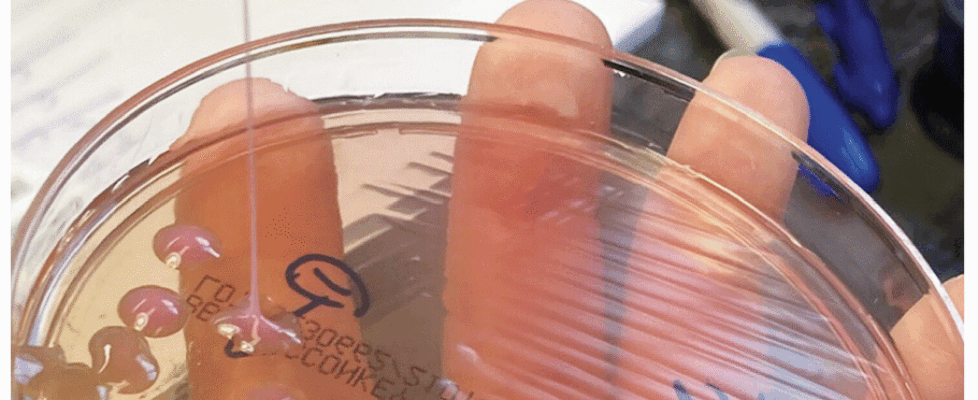

This may be the grossest eye pic ever—but the cause is what’s truly horrifying
A generally healthy 63-year-old man in the New England area went to the hospital with a fever, cough, and vision problems in his right eye. What his doctors eventually figured out was that a dreaded hypervirulent bacteria—which is rising globally—was ravaging several of his organs, including his brain.
According to the man, the problems had started three weeks before his hospital visit, when he said he ate some bad meat and started having vomiting and diarrhea. Those symptoms faded after about two weeks, but then new problems began; he started coughing and having chills and a fever. His cough only worsened from there.
At the hospital, doctors took X-rays and computed tomography (CT) scans of his chest and abdomen. The images revealed over 15 nodules and masses in his lungs. But, that’s not all they found. The imaging also revealed a mass in his liver that was 8.6 cm in diameter (about 3.4 inches). Lab work pointed toward an infection. So, doctors admitted him to the hospital and provided oxygen to help with his breathing, as well as antibiotics. But, his chills and cough continued.